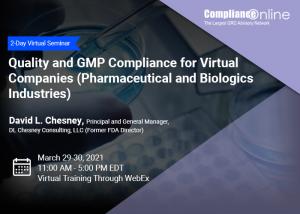

ComplianceOnline Kicks Off Seminar on ‘Quality and GMP Compliance for Pharmaceutical and Biologics Industries'
"Quality and GMP Compliance for Virtual Companies (Pharmaceutical and Biologics Industries)" Seminar has been added to ComplianceOnline.com's offering.
SAN JOSE, CALIFORNIA, UNITED STATES, March 17, 2021 /EINPresswire.com/ -- ComplianceOnline, the largest GRC Advisory Network has officially launched registration for the Seminar 'Quality and GMP Compliance for Virtual Companies (Pharmaceutical and Biologics Industries).' This virtual event will be held on March 29-30, 2021 (11:00 AM - 5:00 PM EDT) and will be presented by Former FDA Director, David L. Chesney.
Today, many companies operate on an outsourcing model. This is very common for companies who are evolving from being mainly development-focused to a point where they are entering latter stages of Phase 2 or Phase 3 clinical trials, and plan to have a product ready for market approval in the coming months. Most such companies are small and may not have deep expertise in QA and GMP compliance, relying on their partners to cover those areas. Companies who outsource most operations through the use of Contract Manufacturing Organizations (CMOs), Contract Research Organizations (CROs) and Contract Laboratories, however, remain responsible for the quality and compliance status of the products they send to the clinic or to the marketplace.
In this two-day workshop conference, participants will learn the requirements and expectations of major health care regulators that are applicable to "virtual" companies. They will learn how to diagnose your company's needs based on which GMP and GCP-governed operations they retain and which they outsource; what the current expectations and best industry practices are for selecting, qualifying and monitoring your contractors to ensure they are meeting your requirements; and how to build a quality system framework that is not excessive for your current needs, but has the structure and integration to "grow with you" as the scope your operations change in the coming months and years. They will also learn best practices for managing a regulatory inspection, with emphasis on FDA, EMA and Health Canada, but applicable to most other major agencies as well.
Learning Objectives:
Participants in this seminar will:
• Understand the GMP and GCP requirements all virtual companies must meet regardless of the extent of their outsourcing operations.
• Understand how to select, qualify and monitor CMOs, CROs and Contract Laboratories
• Learn the elements to include in a quality agreement (also known as a technical agreement)
• Learn how to determine which GMP or GCP requirements apply to you, depending on the things you do internally and those you outsource.
• Understand your obligations under the law for products you release to the clinic or the marketplace.
• Appreciate the importance of maintaining data integrity.
• Learn how to effectively manage a health regulatory inspection:
o Inspection logistics
o Responding effectively to document requests and questions from inspectors
o Managing the inspection exit discussion.
o How to write an effective response to inspection observations
o How to find applicable inspection references and procedures of the FDA, EMA and Health Canada
Who will Benefit:
This course is designed for those charged with managing Quality Assurance and Regulatory Affairs for companies in the development or commercial phase of growth who either release investigational drugs to clinical trial sites or send commercial products to the market but rely to a great extent on the use of Contract Manufacturers and/or Contract Laboratories. The following personnel will benefit from the course:
• Senior quality managers in manufacturing QA/GMP or clinical quality areas
• Quality professionals
• Regulatory professionals
• Clinical Operations
• Compliance professionals
• Quality auditors – GMP and GCP
• Document control specialists
For more information or to register for this seminar, please click here.
Virtual Training Through WebEx
Date: March 29-30, 2021 (11:00 AM - 5:00 PM EDT)
About the Speaker:
David L. Chesney, MSJ, is the Principal and General Manager for DL Chesney Consulting, LLC, providing GMP and GCP compliance consulting and training services to clients worldwide. He has 47 years’ experience, evenly divided between the FDA and the private sector, including over 20 years as Vice President, Strategic Compliance Services for PAREXEL Consulting. Prior to joining PAREXEL Consulting, he served 23 years with the FDA as an Investigator, Supervisory Investigator, Director of Investigations and ultimately as District Director in San Francisco, managing all FDA operations in Northern California, Nevada and Hawaii.
Mr. Chesney has an MS degree in Jurisprudence, concentrating in Pharmaceutical and Medical Device Law from Seton Hall University School of Law, a bachelor’s degree in Biology from California State University, Northridge, plus three years of graduate study in Biology at CSU Northridge and CSU San Diego. Mr. Chesney is a member of the Parenteral Drug Association, where he serves on the faculty of the PDA Training and Research Institute. He is also active in the Food and Drug Law Institute and RAPS.
About ComplianceOnline.com:
ComplianceOnline is a leading provider of regulatory compliance training programs for companies and professionals in regulated industries. ComplianceOnline has successfully trained over 55,000 professionals from 15,000 companies to comply with the requirements of regulatory agencies. ComplianceOnline is headquartered in Palo Alto, California, and can be reached at http://www.complianceonline.com. ComplianceOnline is a MetricStream portal. MetricStream (www.metricstream.com) is a market leader in Enterprise-wide Governance, Risk, Compliance (GRC), and Quality Management Solutions for global corporations.
For more information on ComplianceOnline or to browse through our training programs, please visit our website
Priyabrata Sahoo
ComplianceOnline
+1-888-717-2436
email us here
Visit us on social media:
Facebook
Twitter
LinkedIn
Legal Disclaimer:
EIN Presswire provides this news content "as is" without warranty of any kind. We do not accept any responsibility or liability for the accuracy, content, images, videos, licenses, completeness, legality, or reliability of the information contained in this article. If you have any complaints or copyright issues related to this article, kindly contact the author above.